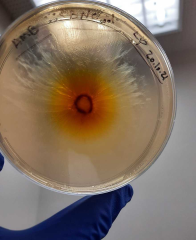

Sustainability
BION is supporting several initatives on climate change and sustainability.
BION is part of this September's City Cycling Initiative in Saarland!
We will collect our bike kilometers to encourage as many people as possible to switch to using their bicycle in their everyday lives and thus make a contribution to climate protection.
Gregor and Kathrin are members of Scientists for Future Saarland.
S4F is an environmental initiative founded by a group of scientists in Germany, Austria, and Switzerland in support of the student movement Fridays for Future
Gregor has signed the Voluntary commitment to refrain from short-haul business flights “I won’t do it under 1,000 km” to set an example for climate protection.
Anyone who wants to support the initiative can sign here.